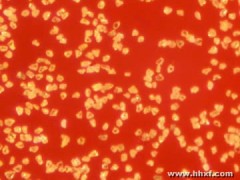

产品价格¥0.50元/克拉
产品品牌旋风
最小起订≥5000 克拉
供货总量10000000 克拉
发货期限自买家付款之日起 3 天内发货
浏览次数244
企业旺铺https://b2b.at78.cn/hhxf600172/
更新日期2017-05-09 09:55
品牌: |
旋风 |
所在地: |
河南 许昌市 |
起订: |
≥5000 克拉 |
供货总量: |
10000000 克拉 |
有效期至: |
长期有效 |
规格: |
0-0.25~54-80 |
本网页所展示的有关【钻石粉_磨具磨料_河南黄河旋风股份有限公司】的信息/图片/参数等由企发网的会员【河南黄河旋风股份有限公司】提供,由企发网会员【河南黄河旋风股份有限公司】自行对信息/图片/参数等的真实性、准确性和合法性负责,本平台(本网站)仅提供展示服务,请谨慎交易,因交易而产生的法律关系及法律纠纷由您自行协商解决,本平台(本网站)对此不承担任何责任。您在本网页可以浏览【钻石粉_磨具磨料_河南黄河旋风股份有限公司】有关的信息/图片/价格等及提供【钻石粉_磨具磨料_河南黄河旋风股份有限公司】的商家公司简介、联系方式等信息。
在您的合法权益受到侵害时,欢迎您向webmaster@at78.cn邮箱发送邮件,或者进入《网站意见反馈》了解投诉处理流程,我们将竭诚为您服务,感谢您对企发网的关注与支持!